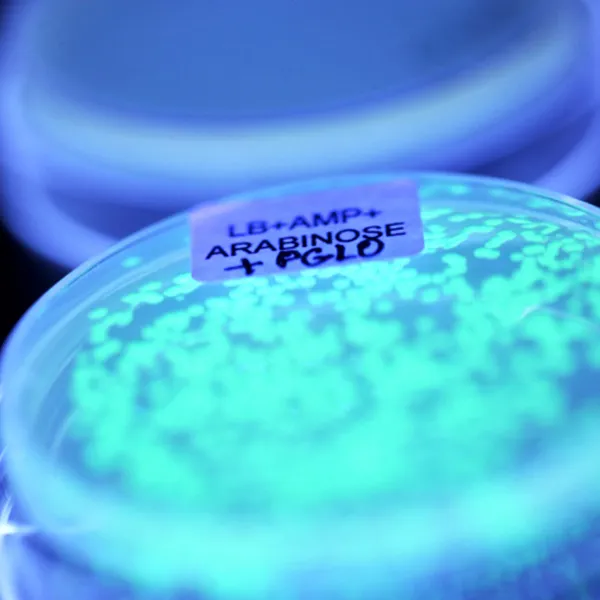
Petri dish that is full of cultured cells of bacteria, that is glowing in the dark.

Biology
Explore the foundations of and interconnection among all living things in one of the top Biology degree programs in Canada.
At Trent, you will have the exceptional experience of exploring underlying theories and concepts of biology through lectures, labs, and fieldwork on Trent's ecologically diverse campus.
Study life up close in Trent’s state-of-the-art Life and Health Sciences Building, or outdoors in our second-to-none outdoor laboratories, including 11 on-campus nature areas. You will build confidence as a biologist, learning alongside world-renowned faculty in small-group environments.
With multiple scholarships, work experience, and student-led research opportunities, Biology students at Trent develop the transferable skills needed for success in a variety of science-based careers in agriculture, health care, wildlife conservation, and technology, to name a few.
Accelerated Masters
Fast-track your education, by earning your M.Sc. in Environmental & Life Sciences in only 12-20 months of graduating from your Honours B.Sc.
Study the living world in one of Canada’s top Biology programs, with hands-on experience in Trent's state-of-the-art Life and Health Science Building and 1,400 acres of Nature Areas.
- Complete an immersive internship or placement opportunity with organizations such as the Ministry of Natural Resources and Forestry (with offices and labs right here on campus!), Parks Canada, Ontario Turtle Conservation Centre, Royal Ontario Museum, Metro Toronto Zoo, Kawartha Land Trust, and Peterborough Field Naturalists, to name a few
- Take immersive field courses held in Canada and around the world through the Ontario Universities Program in Field Biology
- Lead your own independent research project mentored by faculty experts at the Trent Centre for Communicating Conservation, or the Molecules, Cells and Systems Research Group
- Access state-of-the-art instrumentation in top labs and research facilities, including advanced microscopes and histology equipment in Trent’s Biology Imaging Suite and DNA profiling facilities

#1 undergraduate university in Ontario
92% Trent Grads employed within six months
#1 undergrad university in Ontario for student services and student awards
Requirements
If you are coming straight from high school in Ontario or are a recent grad, the general admission requirements are:
- Ontario Secondary School Diploma (OSSD)
- A minimum of six Grade 12 4U or 4M courses, including program specific prerequisites
- A minimum 70% overall final average
- ENG 4U with a minimum of 60%
Program specific requirements:
- SBI4U and SCH4U
Requirements
Students from across Canada can use their grades from their home province to apply to Trent.
Requirements
International students from outside Canada can apply based on the curriculum of their home country.
Requirements
Mature students can apply to Trent based on previous education and professional or volunteer experience.
Requirements
With many transfer agreements and flexible pathway options, Trent University makes it easy for students to make the most of the credits you have already earned.
Whether you're graduating from an Ontario high school, looking to study in Canada, or training for a second career, Trent has clear pathways for students to apply and be admitted to study at either of our campuses.